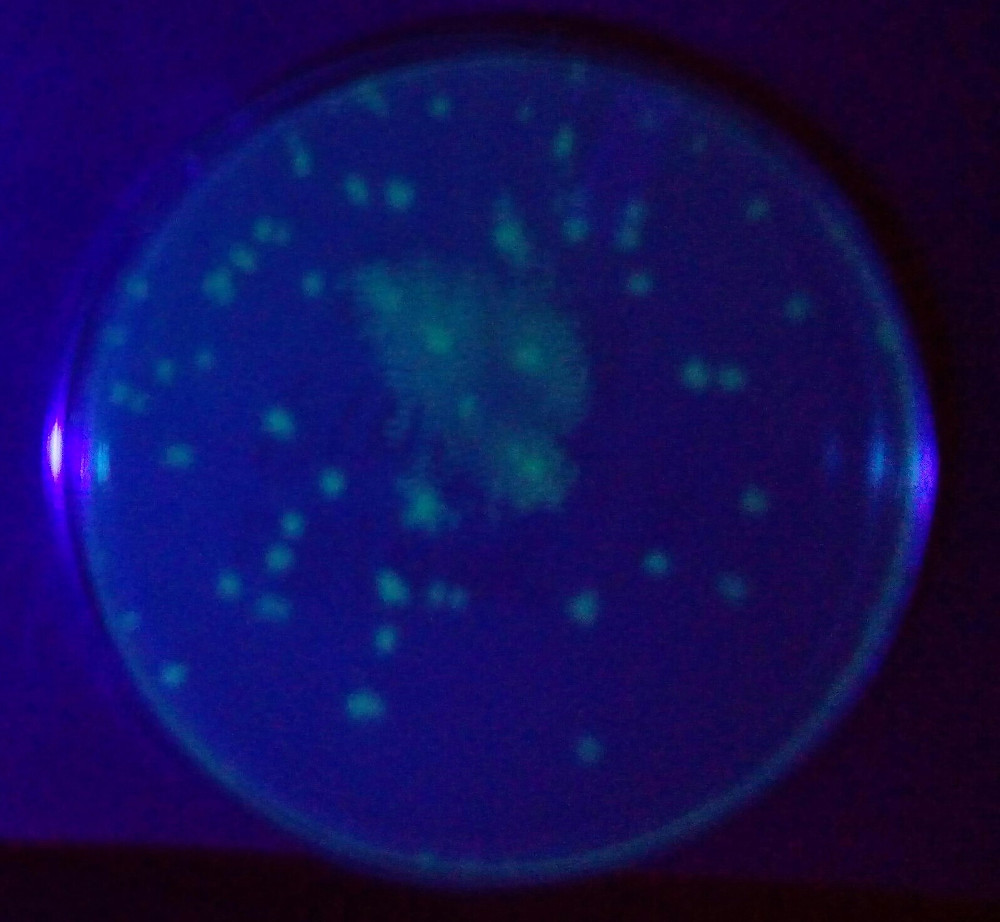

68 — Biotechnology STEM in Practice - a PTA Thrift Shop Funded Project.
2016-04-17. By Kelly.
Fig. 1. E.coli Transformation Lab Completed 4/15/2016.
We are just finishing up our Biotechnology Unit. It has been an exciting experience. We started the unit by learning about Green Fluorescent Protein (GFP) and how GFP is used by scientists. After gaining a firm understanding of GFP, we learned about the process necessary to bioengineer our E Coli into GFP E.coli. Bacteria that have a protein inserted into their DNA that make them glow with a UV light. We also wanted our student to understand the real world application of creating a genetically modified organism. Therefore we used a virtual lab to learn about the process that is used by biotechnology companies to create GMOs (genetically modified organisms).
After building our foundation, we were able to roll up our sleeves and gain lab skills necessary to successfully transform our bacteria into GFP E.coli. The student completed a lab practical in which they did each of the steps necessary to transform their bacteria into glowing green bacteria. This time was essential for students to Learn how to work as a group and to learn how monitor each step of the procedure to ensure that their sample was properly prepared for the transformation. Taking time to do a lab practical yielded amazing results. Every group was able to transform their bacteria into glowing green bacteria.
The STEM biotechnology experience would not be possible without a generous grant from the PTA Thrift shop. Because of the grant, we were able to provide the materials for 275, 8th grade students to participate in biotechnology lab that transformed E.coli into GFP E.coli. We cannot describe how wonderful it is to provide this hands on lab experience to all our students. Not all of our students will continue on to participate in higher level science classes in high school and college. Therefore it is important to give each student the fundamentals about bioengineering that will help prepare them for sound decision making in the future.
The images below show students completing the steps for the E.coli Transformation Lab.

Fig. 2. Adding the E.coli.

Fig. 3. Setting up the solution to make the E.coli competent.

Fig. 4. Setting the E.coli sample with the plasmid in the heat bath.